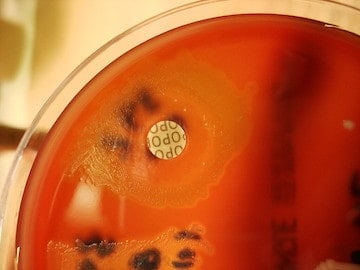
img

Covid-19
COVID-19, caused by the novel coronavirus SARS-CoV-2, has claimed millions of lives and diminished health and well-being around the world since it emerged in 2019. One Health Trust leads the largest epidemiological studies of COVID-19 in the world. OHT is committed to sharing evidence-based research and recommendations with the public to help curb the spread, aid in recovery efforts, and prepare for future pandemics.

Malaria
Malaria leads to impairment and thousands of deaths every year, primarily in low- and middle-income countries. One Health Trust’s research on malaria addresses questions of vector control, policy analysis, and vaccine development and efficacy.